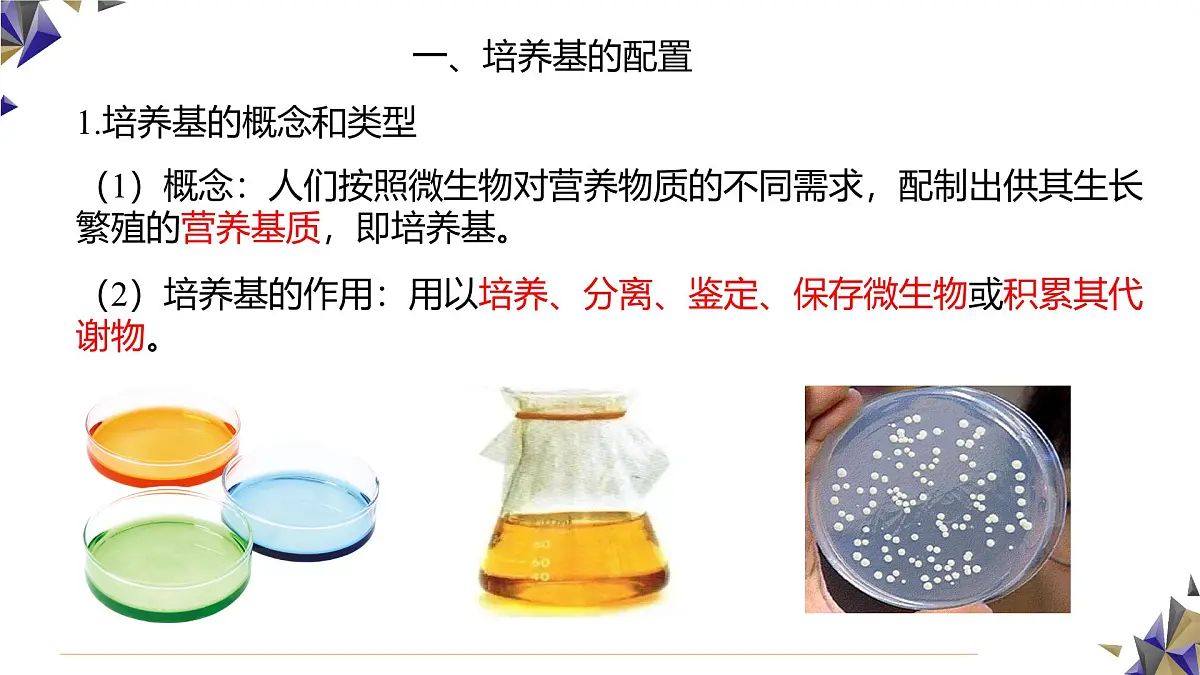
人教版高中生物选修3 1-2《微生物的基本培养技术》第1课时 课件第5页

所属成套资源:人教版高中生物选修3 课件+教案+试题
高中生物人教版 (2019)选择性必修3微生物的基本培养技术评课课件ppt
展开 这是一份高中生物人教版 (2019)选择性必修3微生物的基本培养技术评课课件ppt,共26页。PPT课件主要包含了问题探讨,无细胞结构生物,原核生物,真核生物,培养基的配置,3培养基的类型,培养基的配制,自养微生物,异养微生物,无菌技术等内容,欢迎下载使用。
向经过杀菌处理的牛奶中添加某些对人体有益的细菌,再经过发酵就可以制成酸奶,由于制作工艺并不复杂,一些人会在家里自制酸奶,自制酸奶虽然方便,但是食用自制酸奶导致肠胃不适的事件屡见不鲜,主要原因是在制作过程中有杂菌混入。那么,怎样才能保证无处不在的杂菌不混入发酵物中呢?
应该先对制作用具和原料进行灭菌处理,再接种纯的菌种,并控制发酵条件,避免杂菌进入。
微生物:难以用肉眼观察的微小生物的统称。
病毒:SARS病毒、新冠病毒等RNA病毒;T2噬菌体等DNA病毒。
细菌:蓝细菌、大肠杆菌、乳酸菌等;放线菌:衣氏放线菌等。
真菌:酵母菌、毛霉等;原生生物:草履虫、变形虫等。
防止杂菌污染,获得纯净的微生物培养物是研究和应用微生物的前提,也是发酵工程的重要基础。
实验室培养微生物的条件: ①要为人们需要的微生物提供合适的营养和环境条件; ②要确保其他微生物无法混入,并将需要的微生物分离出来。
1.培养基的概念和类型
(1)概念:人们按照微生物对营养物质的不同需求,配制出供其生长繁殖的营养基质,即培养基。
(2)培养基的作用:用以培养、分离、鉴定、保存微生物或积累其代谢物。
(1)基本成分:水、碳源、氮源、无机盐。
无机碳源:CO2、CO32-、HCO3-。
有机碳源:葡萄糖、牛肉膏、蛋白胨等。
无机氮源:NH4+、NO3-、NH3等。
有机氮源:牛肉膏、蛋白胨、尿素、氨基酸等。
注意:含C、H、O、N的有机物是异养型微生物的碳源、氮源、能源。如氨基酸等。
为什么培养基需要氮源?
培养基中的氮元素是微生物合成蛋白质、核酸等物质所必需的。
(2)特殊需求:某些微生物对pH、特殊营养物质以及O2的需求。
特殊营养物质:维生素、氨基酸、嘌呤、嘧啶等。
(牛肉膏、酵母膏、蛋白胨中含有)
①培养乳酸杆菌时,需要在培养基中添加维生素;②培养霉菌时,需要将培养基调至酸性;③培养细菌时,需要将培养基调至中性或弱碱性;④培养厌氧微生物时,需要提供无氧的条件。
获得纯净的微生物培养物的关键是防止杂菌污染。
无菌技术应围绕着如何避免杂菌的污染展开,主要包括消毒和灭菌。
消毒和灭菌工作的两个方面: (1)对实验操作的空间、操作者的衣着和手,进行清洁和消毒。 (2)将用于微生物培养的器皿、接种用具和培养基等进行灭菌。
注意:避免已经灭菌处理的材料用具与周围的物品接触。为了避免周围环境中微生物的污染,操作都应在超净工作台并在酒精灯火焰附近进行。
无菌技术除用来防止实验室的培养物被其他外来微生物污染外,还有什么作用?
无菌技术还能有效避免操作者被微生物感染。
(1)概念:指使用较为温和的物理、化学或生物等方法杀死物体表面或内部一部分微生物。
①煮沸消毒法:100℃煮沸5~6min,可以杀死微生物的营养细胞和一部分芽孢。
②巴氏消毒法:62~65℃下消毒30 min或80~90℃处理30s~1min,适合一些不耐高温的液体,如牛奶。可以杀死牛奶中的绝大多数微生物,并且不破坏牛奶的营养成分。
③化学药剂消毒法:用70%酒精擦拭双手、用氯气消毒水源等。
④紫外线消毒法:接种室、接种箱或超净工作台在使用前可用紫外线照射30min。在照射前,适量喷洒石碳酸或煤酚皂溶液等消毒液,可以加强消毒效果。
(1)概念:指使用强烈的理化方法杀死物体内外所有的微生物,包括芽孢和孢子。
①湿热灭菌:利用沸水、流通蒸汽或高压蒸汽进行灭菌的方法。高压蒸汽灭菌效果最好,100 kPa、121℃下维持15~30min,常用于培养基、无菌水等的灭菌。
②干热灭菌:将灭菌物品放入密闭容器如干热灭菌箱,在160~170℃的热空气中维持2~3h。常用于耐高温的和需要保持干燥的物品(如玻璃器皿、金属用具等)。
③灼烧灭菌:将微生物的接种工具,如涂布器、接种环、接种针或其它金属用具,直接在酒精灯火焰的充分燃烧层(外焰)灼烧,可以迅速彻底地灭菌。此外,在接种过程中,试管口、瓶口等容易被污染的部位,也可以通过火焰灼烧来灭菌。
在微生物学中,将接种于培养基内,在合适条件下形成的含特定种类微生物的群体称为培养物。
2.微生物的纯培养步骤:(1)配置培养基;(2)灭菌;(3)接种;(4)分离和培养。
1.微生物的纯培养的概念:由单一个体繁殖所获得的微生物群体称为纯培养物,获得纯培养物的过程就是纯培养。
探究·实践·酵母菌的纯培养
菌落:分散的微生物在适宜的固体培养基表面或内部可以繁殖形成肉眼可见的、有一定形态结构的子细胞群体,这就是菌落。
2.获得单菌落的方法:采用平板划线法和稀释涂布平板法将单个微生物分散在固体培养基上,之后得到的单菌落一般是由单个微生物形成的纯培养物。
称取去皮马铃薯200g,切成小块,加水1000ml,加热煮沸至马铃薯软烂,用纱布过滤。向滤液中加入20g葡萄糖、15~20g琼脂,用蒸馏水定容至1000ml。
将配制好的培养基转移到锥形瓶中,加棉塞,包上牛皮纸,并用皮筋勒紧,再放入高压蒸汽灭菌锅中,在压力为100kPa、温度为121℃的条件下,灭菌15~30min。将5~8套培养皿包成一包,用几层牛皮纸包紧,放入干热灭菌箱内,在160~170℃灭菌2h。
待培养基冷却到50℃左右时,在酒精灯火焰附近倒平板。
③用拇指和食指将培养皿打开一条稍大于瓶口的缝隙,将培养基(10~20mL)倒入培养皿,立即盖上皿盖
④等待培养基冷却凝固后,将培养皿倒转过来放置
既可以防止培养基表面的水分挥发;又可以防止皿盖上的水珠落入培养基,造成污染。
(2)接种和分离酵母菌
通过接种环在固体培养基表面连续划线的操作,将聚集的菌种逐步稀释分散到培养基表面。经数次划线后培养,可以分离得到单菌落。
①灼烧接种环,直至接种环金属丝烧红
②在火焰旁冷却接种环,拔出酵母菌培养液试管的棉塞
④在火焰附近用接种环蘸取一环菌液
⑤试管口通过火焰,并塞上棉塞
⑥将皿盖打开一条缝隙,用接种环在培养基表面迅速划三至五条平行线,盖上皿盖
⑦灼烧接种环,待其冷却后,从第一次划线的末端开始作第二次划线。重复以上操作,作第三、四、五次划线
(平板划线法的具体操作)
注意:①接种环只蘸一次菌液,但要在培养基不同位置连续划线多次;②划线首尾不能相接;③每次划线前接种环进行灭菌;④划线后,培养皿倒置培养。
为什么在操作的第一步以及每次划线之前都要灼烧接种环?在划线操作结束时,仍然需要灼烧接种环吗?为什么?
杀死接种环上原有微生物
杀死上次划线时残留菌种,使下一次划线的菌种直接来源上次划线的末端,从而使每次划线时菌种数目逐渐减少,直至得到单个细胞
杀死接种环上残留的菌种,避免细菌污染环境和感染操作者
完成平板划线后,待菌液被培养基吸收,将接种后的平板和一个未接种的平板倒置,放入28℃左右(培养温度因酵母菌种类的不同而稍有差异)的恒温培养箱中培养24~48h。
1.在未接种的培养基表面是否有菌落生长?如果有,说明了什么?2.在接种酵母菌的培养基上,你是否观察到了单菌落?这些菌落的颜色、形状和大小是否一致?如果你观察到了不同形态的菌落,你能分析出可能是由哪些原因引起的吗?
在未接种的培养基表面应该没有菌落生长,如果有,说明培养基被杂菌污染。
如果观察到了不同形态的菌落,可能是接种的菌种不纯或者无菌操作不规范等原因引起的。
思维训练·评估论点的可信程度
所谓“酵素”,就是“酶”的另一种说法。“酵素”制作就是利用微生物进行无氧呼吸的原理,进行像制作泡菜一样的发酵。 这样制作的“酵素”中可能有糖类(包括-些简单的糖和膳食纤维等)、蛋白质(包括多种酶)、有机酸等成分,不存在它独有的、特殊的营养物质,其中甚至可能含有微生物发酵产生的有毒物质,食用后可能会危害人体健康。因此,“吃水果酵素可以美容、减肥、促进消化和提高免疫力”的论点值得怀疑。
1.下列有关微生物营养物质的叙述中,正确的是( ) A.是碳源的物质不可能同时是氮源 B.凡碳源都提供能量 C.除水以外的无机物只提供无机盐 D.无机氮源也能提供能量2.下列关于灭菌和消毒的说法不正确的是( ) A.灭菌是指杀死环境中的所有微生物,包括芽孢和孢子 B.灭菌和消毒实质上是相同的 C.接种环用灼烧法灭菌 D.常用的灭菌方法有灼烧灭菌、干热灭菌、湿热灭菌等
3.养殖池中存在的有毒物质,主要是氨及亚硝酸,这两种物质可被硝化细菌吸收利用。在“养殖池底泥中硝化细菌的分离与计数”实验中,说法正确的是( ) A.需要配制添加一定浓度氨盐的牛肉膏蛋白胨培养基,以筛选硝化细菌 B.应对采集底泥使用的工具进行灭菌,全部接种过程均需在酒精灯火焰旁进行 C.可以采用平板划线法进行接种,还需与未接种的空白培养基同时培养 D.应将接种后的培养基放在光照培养箱中培养,原因是硝化细菌为生产者
相关课件
这是一份高中生物人教版 (2019)选择性必修3微生物的基本培养技术评课课件ppt,共26页。PPT课件主要包含了问题探讨,无细胞结构生物,原核生物,真核生物,培养基的配置,3培养基的类型,培养基的配制,自养微生物,异养微生物,无菌技术等内容,欢迎下载使用。
这是一份高中生物人教版 (2019)选择性必修3微生物的基本培养技术教学课件ppt,共19页。PPT课件主要包含了从社会中来,微生物,非细胞类,霉菌等,原生生物,类病毒等,培养基,无菌技术,基本成分,1碳源等内容,欢迎下载使用。
这是一份人教版 (2019)选择性必修3微生物的基本培养技术教学课件ppt,共44页。PPT课件主要包含了酵母菌的纯培养,1原理,2材料用具,①配制培养基,3方法步骤,②灭菌,③倒平板,课堂练习,培养基,高压蒸汽灭菌等内容,欢迎下载使用。
相关课件 更多
- 1.电子资料成功下载后不支持退换,如发现资料有内容错误问题请联系客服,如若属实,我们会补偿您的损失
- 2.压缩包下载后请先用软件解压,再使用对应软件打开;软件版本较低时请及时更新
- 3.资料下载成功后可在60天以内免费重复下载
免费领取教师福利 






.png)




